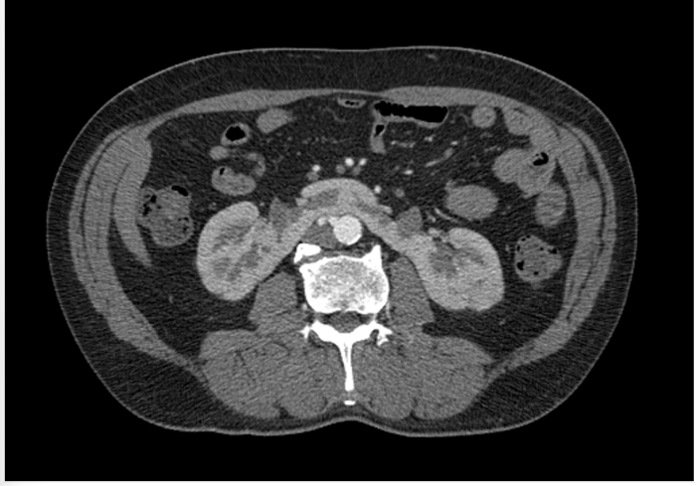
Enunciado 4478616-1

Analise a imagem de tomografia computadorizada abaixo e avalie as assertivas que seguem.
Figura 4 –Tomografia computadorizada do rim.

Fonte: CPCON.
I- A imagem corresponde à anomalia de fusão denominada rim em ferradura, em que há a fusão dos polos inferiores dos rins na linha média.
II- O achado acima é compatível com rim discoide. Nesses casos, a drenagem ureteral sempre é feita por ureter único.
III- Pacientes que apresentam esta anormalidade de fusão têm aumento da incidência de neoplasias, como carcinoma de células transicionais.
IV- Trata-se de uma ectopia renal cruzada com fusão.
V- O local onde há a fusão pode apresentar tecido fibroso ou parênquima renal.
É CORRETO o que se afirma apenas em:
Figura 4 –Tomografia computadorizada do rim.
Fonte: CPCON.
I- A imagem corresponde à anomalia de fusão denominada rim em ferradura, em que há a fusão dos polos inferiores dos rins na linha média.
II- O achado acima é compatível com rim discoide. Nesses casos, a drenagem ureteral sempre é feita por ureter único.
III- Pacientes que apresentam esta anormalidade de fusão têm aumento da incidência de neoplasias, como carcinoma de células transicionais.
IV- Trata-se de uma ectopia renal cruzada com fusão.
V- O local onde há a fusão pode apresentar tecido fibroso ou parênquima renal.
É CORRETO o que se afirma apenas em: